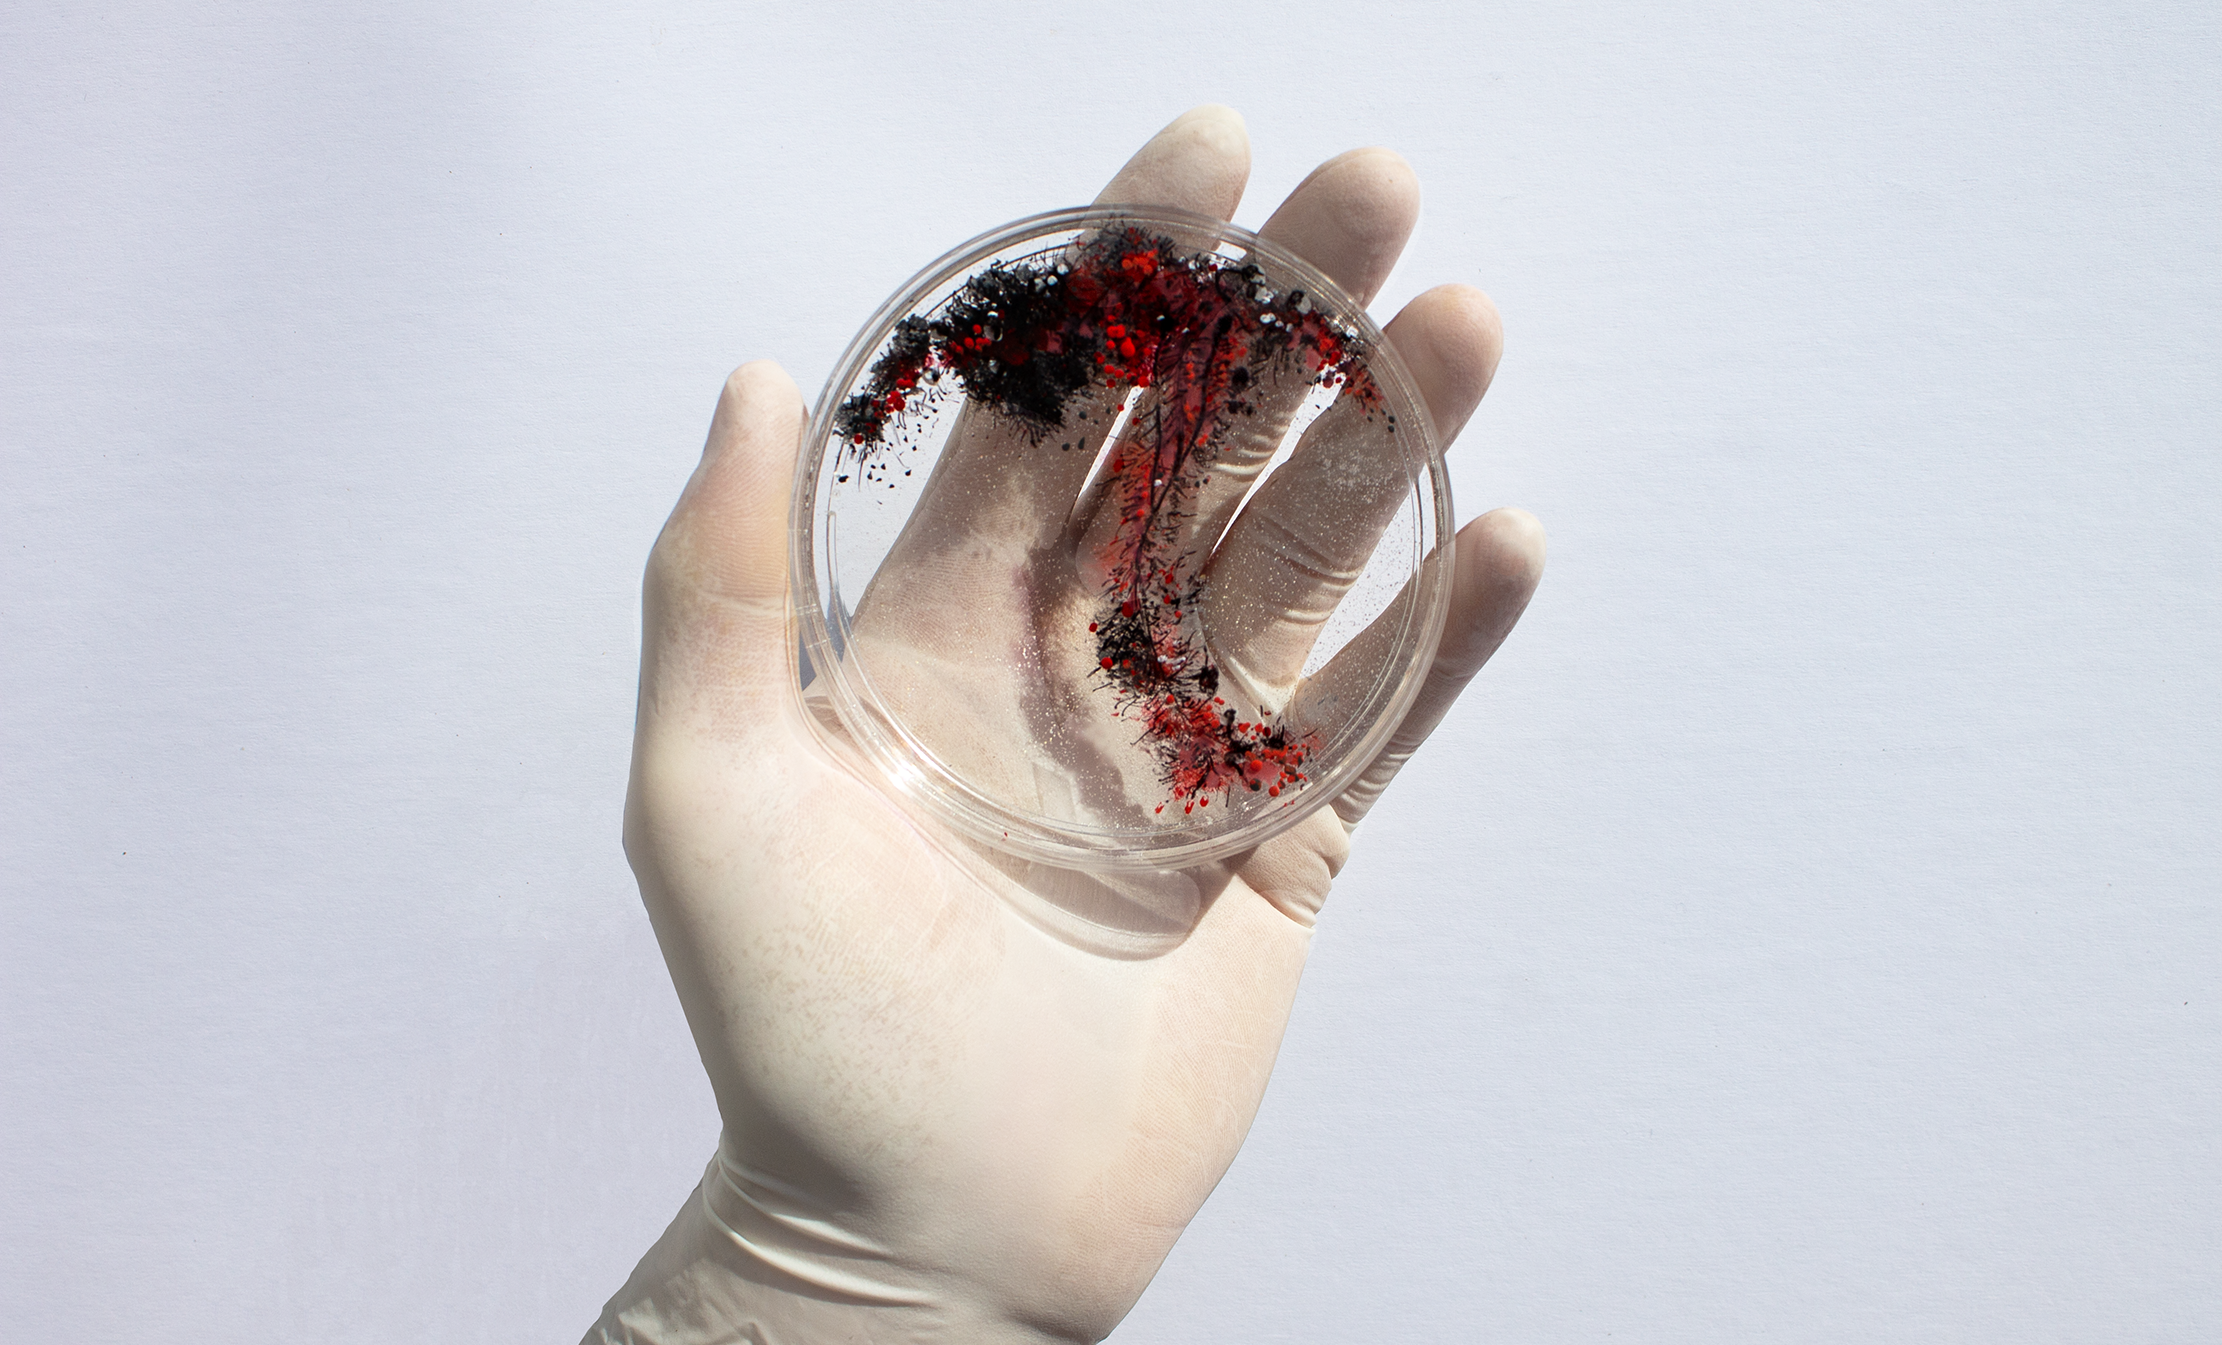

Illustration
2019-2024Game Blog Header
A digital illustration exploring the world of board games for a client.
Grandma’s Chicken Salad
A surreal digital illustration for a client’s cookbook.
Work Hard
Just something fun.
Digital Collage
Evergreen collage work for client.
Tools - Procreate, Photoshop, Illustrator




Sohn Studio
Branding | 2019“Dawn is the time when nothing breathes, the hour of silence. Everything is transfixed, only the light moves” –Leonora Carrington
Sohn Studio’s philosophy is centered around unconvering the truth in design. The abstracted colors of dawn is symbolic of light dissapting darkness. Inspired by German philosophers and religious texts, I decided to use the German word "Sohn", which stands for "Son" in English. The studio strives to mix genuine emotion with experimental methods and peculiar twists.
Featured:
Brand Teaser
Wordplay
Sun Symbols
Canvas Totes
Posters
Business Cards
Tools - PS, AI, ID, C4D





Unconventional Alphabet
Handlettering | 2019A handlettering project that focuses on experimenting with organic letterforms. I took inspiration from the shapes and growth patterns of bacteria/mold and created an alphabet.
Tools - paint, resin, blowtorch, petri dish

Ah! Robots Festival
Branding, C4D | 2020Ah! Robots is an underground festival that combines electronic music and bot fighting. Attendants can participate in digital card trading, robot building, or bot fighting – all while listening to the top EDM DJs.
Featured:
Digital Motion Trading Cards
Robot Design
Festival Posters
Environmental Design
Tools - C4D, Photoshop, ID






White Keys Vodka
Limited Edition Packaging | 2019An unorthodox collaboration celebrating White Keys Vodka and architect Ricardo Bofill. Showcased is a limited edition vodka to commemorate Bofill’s life’s work. The structure was inspired by his love for dynamic space, juxtaposition, repetition, and geometric pattern.
Tools - Wood, Paint, Paper, Double sided tape, Bottle

